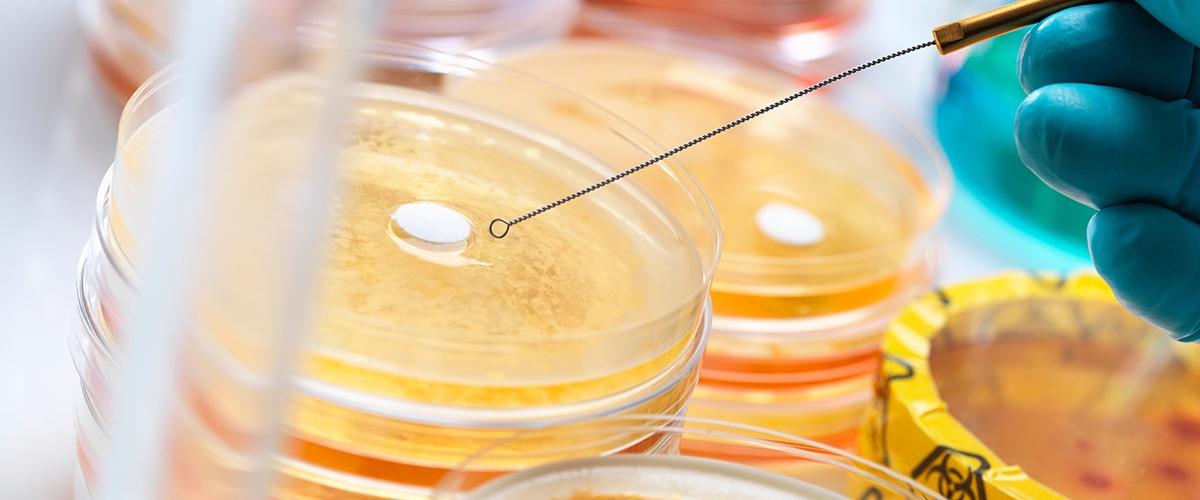
TODO:

Каждый раз, когда антибиотик уничтожает колонию бактерий, несколько наиболее выносливых особей выживают и передают свои гены потомкам. Со временем доля устойчивых микроорганизмов в популяции растет, и старый препарат перестает действовать.
Но есть и другой, более хитроумный способ приобрести резистентность к антибиотикам. Часть генома бактерий представлена в виде плазмид — небольших фрагментов ДНК, которыми они могут обмениваться между собой. Этот процесс, известный как горизонтальный перенос генов, помогает бактерии, выработавшей устойчивость, поделиться своим навыком с другими особями.
По словам ученых, именно горизонтальный перенос служит ключевым механизмом распространения антибиотик-резистентных инфекций.
Исследователи из Университета Вашингтона в Сент-Луисе решили использовать его в качестве мишени для новых препаратов.
Как сообщает New Atlas, ученые сосредоточились на плазмидах бактерии Acinetobacter baumannii, которая считается особенно опасной, поскольку приобрела устойчивость ко всем основным антибиотикам. Команда обнаружила, что у этого микроорганизма есть инструмент для убийства других бактерий, которые расположены слишком близко. Когда он включается, горизонтальный перенос генов не работает, и наоборот.
Исследователи создали модифицированные плазмиды, которые не ограничивают способность ацинетобактера защищать себя от других бактерий, а также изменили геном самой бактерии, сделав «режим убийства» постоянным. В обоих случаях плазмиды и, следовательно, гены устойчивости к антибиотикам, не могли распространяться.
Хотя ученым и удалось нащупать слабое место бактерий, генно-модифицированные штаммы вряд ли смогут серьезно потеснить своих диких собратьев.
Исследователи надеются, что им удастся разработать соединения, которые будут имитировать эффект модификации. Тогда их можно включить в состав новых дезинфицирующих средств.
Устойчивость к антибиотикам может превращать в опасных убийц даже те болезни, с которыми человечество научилось бороться, например, туберкулез. Исследователи из Ирландии создали специальный ингалятор, который позволяет победить резистентные формы этой болезни.